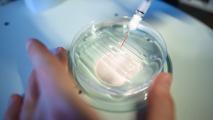

DNA extracted from a prehistoric human tooth shows that hepatitis B has been infecting humans for at least 7,000 years. It’s the oldest human virus ever to be sequenced, scooping the previous record of 4,500 years (set by another paper released the same week!). Ancient viral DNA in humans is a huge discovery: a fossil record for the evolution of disease. Tracing the history, spread, and variation of viruses around the world will help scientists understand how new viruses emerge and evolve and how to fight them.
B for Bad News
Discovered in humans in 1967, hepatitis B is an incurable virus that targets the liver. A vaccine was approved in 1982, but, unlike polio and smallpox, the virus is still a worldwide scourge. 800,000 people die from it every year, and 250 million people are living with an infection. Polio and smallpox infections could spread more easily, but only for about a month, whereas chronic hep B is a lifetime infection that is always communicable.
Jumping the Species Barrier?
According to a trio of new papers, hepatitis had been with us for thousands of years by the time it was discovered in the 1960s. Researchers scoured human bones from 200 to 7,000 years ago, across Europe and Asia, looking for the virus. They found it virtually everywhere, back to at least 5,000 BCE. But some of it was weird. Ancient hepatitis in Asia was similar to what infects people everywhere today, while prehistoric Europeans had a strain that has gone totally extinct, at least in humans. But it looks a lot like a virus that today infects gorillas and chimpanzees in Africa. How did it get from African apes to humans in Europe but skip Asia? Or did it go the other way? It’s also impossible to say yet why one strain died out and another persisted worldwide for thousands of years. But the clues are fascinating.
Dumpster Diving for Hepatitis? Ew.
Scientists have already been extracting ancient human DNA for years. But to isolate human genomes from ancient teeth or bones, they have to read all of the DNA in the sample, including contamination from stuff like bacteria, plants, fungi, animals, and (yup) viruses. Then they throw out everything that isn’t human and use algorithms to piece together the rest of it.
But that stuff in the trash turned out to be super valuable, because it contains all sorts of ancient viral infections, too. Researchers can just go dumpster diving for ancient human viruses in the data they already have. That’s especially good news, because the process of sequencing DNA from old samples usually destroys it, which means you’ve only got the one shot at it.
What It Means
This is just the start. Researchers are now looking for DNA from dozens of other viruses in ancient humans, like smallpox, the common cold, and herpes. We’ve only been studying viral DNA for a few decades, so we’ve been missing most of the history of human-virus warfare (except for scarred fossils and traces left in our current DNA). Getting a timeline of how and where viruses evolved (and how human DNA adapted to resist them) could lead to breakthroughs in treating, preventing, and predicting outbreaks. It’s even possible, one scientist told The Atlantic, that we could synthesize ancient viruses and study how they affect mice to get a picture of how they differ from modern strains. In any case, in the fight against death and disease, knowledge is power, and we’ve just cracked open thousands of years of new knowledge.